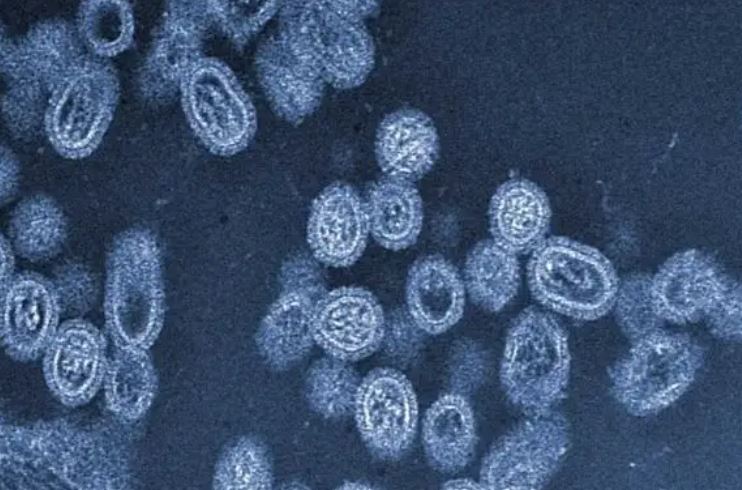

રોગચાળો વકર્યો: અમદાવાદ શહેરમાં ઝાડા-ઉલટીના કેસ વધ્યા,સૌથી વધુ બાળકો બીમાર
શહેરમાં રોગચાળાએ માથુ ઉંચક્યું સૌથી વધુ બાળકો બીમાર ઝાડા-ઉલટીના વધ્યા કેસ અમદાવાદ:હાલ ઉનાળાની ઋતુ ચાલી રહી છે.જેને પગલે લોકો બીમાર પડતા હોય છે.આવી કાળઝાળ ગરમીમાં બાળકોના સ્વાસ્થ્યને લઈને સાવધાની રાખવી અત્યંત જરૂરી બની છે.લૂ લાગવાથી નાનેરા થી લઇ મોટેરા સુધીના લોકો તાવ,ઝાડા-ઉલટી સહિતના રોગોની ચપેટમાં આવતા હોય છે. અમદાવાદની સોલા સિવિલ હોસ્પિટલમાં ઝાડા ઉલટીના કેસમાં […]